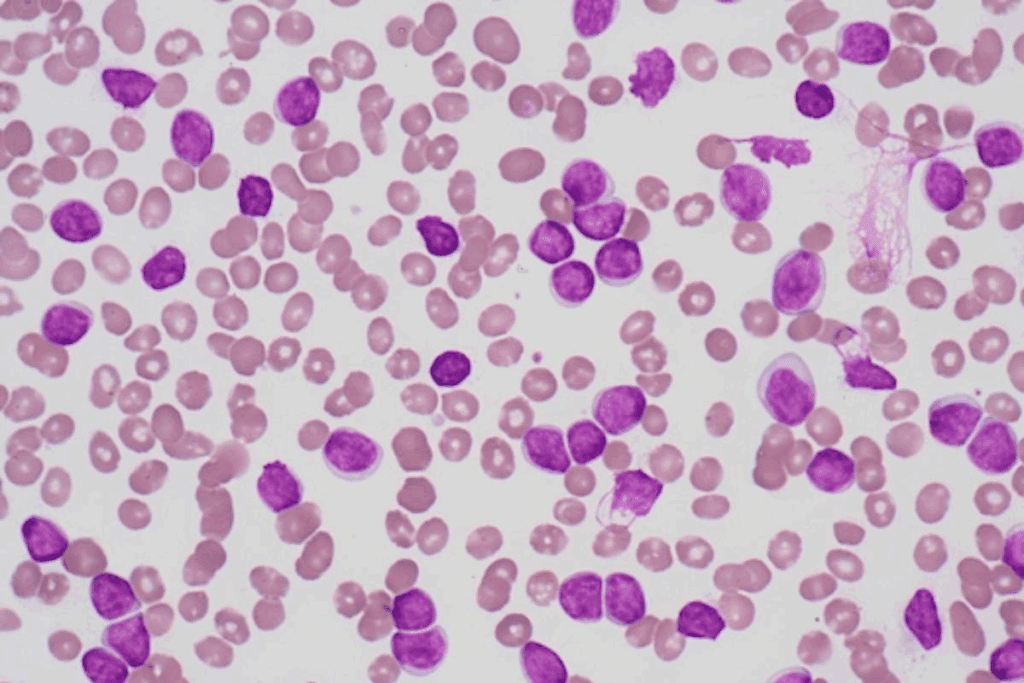
Highest cancer survival rates: Ultimate Hopeful List 2 Highest cancer survival rates: Ultimate Hopeful List

Last Updated on December 1, 2025 by Bilal Hasdemir

Medical treatments have gotten better, leading to higher cancer survival statistics. Now, some cancers have survival rates that give hope to people all over the world.
New therapies and ways to find cancer early have changed top cancer survival outcomes. Knowing these stats is important for both patients and doctors.
We will look at the three cancers with the best survival rates. We’ll talk about what makes these outcomes so positive.
Key Takeaways
- Recent advancements have led to improved cancer survival rates.
- Certain cancers now have significantly higher survival rates than others.
- Understanding survival statistics can aid in patient decision-making.
- Early detection and innovative therapies are key factors in improved outcomes.
- We will explore the top 3 cancers with the highest survival rates.
The Significance of Cancer Survival Statistics
Cancer survival statistics play a crucial role in informing treatment decisions and enhancing patient outcomes. They show how well different treatments work. They also help us find ways to make cancer care better.
Impact on Treatment Decisions
Survival rates help us decide on treatments by showing what to expect from different cancers. For example, thyroid cancer has high survival rates because we know how to treat it well. These stats help us plan treatments and tell patients what to expect.
Groups like Blood Cancer United have made big strides in blood cancer treatment. They’ve helped raise survival rates. Their work shows how important research and support are in improving cancer care.
Recent Improvements in Cancer Outcomes
In recent years, cancer treatment has gotten much better, leading to higher survival rates. We can track these gains and see trends in cancer outcomes thanks to advances in medical oncology statistics. Here are some recent gains in survival rates:
| Cancer Type | Previous 5-Year Survival Rate | Current 5-Year Survival Rate | Improvement |
| Thyroid Cancer | 95% | 97% | 2% |
| Prostate Cancer | 92% | 94% | 2% |
| Testicular Cancer | 95% | 96% | 1% |
These gains show how far we’ve come in cancer research and treatment. By keeping up with survival rates and treatment success, we can make cancer care even better. This will lead to better results for patients.
We’re dedicated to using these insights to make cancer treatment more effective. We want to improve the lives of patients everywhere. Through research and teamwork, we aim to keep making cancer survival rates better.
Understanding How Cancer Survival Rates Are Measured

Measuring cancer survival rates is key to checking how well treatments work. These rates tell us how likely patients are to survive certain cancers. They help doctors and patients make better choices about care.
Five-Year Survival Rate Explained
The five-year survival rate is a key way to measure cancer survival. It shows the percentage of people who live for five years after being diagnosed. For example, an 80% rate means 80% of patients with that cancer might live for five years.
But, it’s important to remember that this rate is an average. Many things can affect how long a person lives with cancer, like the cancer’s stage and the treatment’s success.
Relative vs. Absolute Survival Rates
It’s important to know the difference between relative survival rates and absolute survival rates. The relative survival rate compares cancer patients to the general population. It shows how well cancer treatments work.
The absolute survival rate just shows the percentage of people who survive a certain time after being diagnosed. Knowing both types of rates helps us understand cancer survival better.
Understanding these concepts helps doctors and patients make better choices about treatment and care.
Factors That Influence Cancer Survival Outcomes
Many factors affect how long people live after being diagnosed with cancer. The stage of cancer and access to new treatments are key. Knowing these helps patients and doctors make better choices.
Stage at Diagnosis
The cancer’s stage at diagnosis is very important. Being diagnosed early usually means better chances and more treatment options. We’ll look at how cancer is staged and its impact on survival.
Table: Cancer Staging and Survival Rates
| Cancer Stage | Typical 5-Year Survival Rate |
| Stage I | 90% |
| Stage II | 60-80% |
| Stage III | 30-50% |
| Stage IV | 10-20% |
Patient Demographics and Health Status
Age, gender, and health also matter a lot. Younger, healthier people usually do better because they can handle tough treatments.
Access to Advanced Treatment Options
Having access to new treatments like targeted and immunotherapies makes a big difference. These treatments are more effective and tailored to each patient, leading to better results.
As a study found,
“Advances in cancer treatment have led to significant improvements in survival rates, particular for patients with access to innovative therapies.”
We’ll keep looking into these factors. This will help us understand how they affect cancer survival rates better.
Overview of the Highest Cancer Survival Rates in Modern Oncology
Medical research has greatly boosted cancer survival rates over time. We’ve seen big changes in how we treat cancer, leading to better patient results and lives. This success shows the hard work of doctors and the growth in cancer research.
How Survival Rates Have Changed Over Time
The Surveillance Research Program, National Cancer Institute, has shown big jumps in cancer survival rates. These gains come from early detection, new treatments, and understanding cancer better. This has led to fewer deaths from cancer, showing how far we’ve come in treating it.
To show how survival rates have changed, let’s look at some numbers:
| Year | Five-Year Survival Rate | Relative Survival Rate |
| 1975 | 48.9% | 50.4% |
| 2000 | 63.4% | 66.1% |
| 2020 | 70.3% | 73.4% |
Comparing U.S. Cancer Outcomes to Global Statistics
When we look at U.S. cancer results versus global data, we see differences. The U.S. has made big strides in cancer treatment, leading to higher survival rates. This is different from some global numbers.
The U.S. is among the top countries for cancer survival rates globally. This is thanks to advanced treatments, strong healthcare, and good cancer screening programs.
We keep an eye on global cancer stats and compare them to U.S. results. This helps us find ways to improve and work together in cancer research.
Thyroid Cancer: The #1 Cancer with Highest Survival Rates
Thyroid cancer has a very high survival rate. This is thanks to better medical tests and treatments. It’s one of the most treatable cancers out there.
Types of Thyroid Cancer and Their Prognosis
There are different types of thyroid cancer, each with its own survival chance. The most common types are papillary, follicular, medullary, and anaplastic. Papillary thyroid cancer is the most common and has a very high survival rate if caught early.
Survival Rates by Type:
| Type of Thyroid Cancer | 5-Year Survival Rate |
| Papillary | 97-99% |
| Follicular | 90-95% |
| Medullary | 80-90% |
| Anaplastic | 7-14% |
Why Thyroid Cancer Is Highly Treatable
Thyroid cancer is treatable because it grows slowly. Early detection is key to successful treatment.
Treatment Approaches and Success Rates
Treatment for thyroid cancer usually includes surgery, radioactive iodine therapy, and thyroid hormone therapy. The treatment plan depends on the cancer type and stage.
Treatment Success Rates:
- Surgery: Highly effective for removing tumors, with a low recurrence rate when performed by experienced surgeons.
- Radioactive Iodine Therapy: Effective in destroying remaining thyroid tissue and cancer cells, improving survival rates.
- Thyroid Hormone Therapy: Helps in reducing the risk of recurrence by suppressing TSH production.
Together, these treatments help thyroid cancer patients have a high survival rate. This makes it one of the cancers with the best outcomes.
Prostate Cancer: The #2 Cancer with Exceptional Survival Statistics
Prostate cancer is the second most survivable cancer, thanks to new medical tech. Survival rates have gone up a lot because of better screening and diagnosis.
Understanding Prostate Cancer Progression
How fast prostate cancer grows can vary a lot. Some tumors grow slowly and stay in the prostate for years. Others grow fast and need quick action. Knowing how it progresses helps doctors choose the right treatment.
The stage of cancer when it’s found is very important. Early-stage cancer is usually treatable. But, cancer that’s more advanced needs more complex treatments.
Screening and Diagnostic Advances
New medical screening techniques have helped a lot. Tests like the PSA test and DRE help find cancer early. This means doctors can treat it before symptoms show up.
Also, new MRI and biopsy methods help doctors diagnose and stage cancer better. These diagnostic advances lead to treatments that are more tailored to each patient. This improves how well patients do.
Treatment Options and Their Effectiveness
Treatment outcome tracking has gotten better, helping manage prostate cancer. There are many treatments, like surgery, radiation, active surveillance, and hormone therapy. The right treatment depends on the cancer’s stage and how aggressive it is, plus the patient’s health.
Research shows men with localized prostate cancer have a 5-year survival rate of almost 100%. Even with regional cancer, the 5-year survival rate is about 95%. These numbers highlight the value of catching cancer early and treating it well.
Testicular Cancer: The #3 Cancer with Remarkable Survival Outcomes
Testicular cancer has seen a big jump in survival rates thanks to better treatments. We’ve made great progress in treating this disease. This has led to a high survival rate for patients.
Types and Stages of Testicular Cancer
There are two main types of testicular cancer: seminoma and non-seminoma. Seminomas are more common and grow slower than non-seminomas. Knowing the type and stage of cancer is key to choosing the right treatment.
Treatment Protocols and Their Evolution
Treatment for testicular cancer has changed a lot over time. We now focus on better survival rates and fewer side effects. The main treatments are surgery, chemotherapy, and radiation therapy. We’ve improved surgery and made chemotherapy more targeted.
Long-term Survival and Quality of Life
Most men with testicular cancer can be cured. But, survivors may face challenges like fertility issues and a higher risk of other cancers. We aim to support patients fully, from treatment to long-term care.
| Type of Testicular Cancer | 5-Year Survival Rate |
| Seminoma | 95% |
| Non-Seminoma | 90-95% |
| Mixed | 92-96% |
Understanding testicular cancer types, stages, and treatments helps us support patients better. Our ongoing work in medical therapy keeps improving testicular cancer survival rates. This gives hope to those fighting this disease.
Comparing the Highest Cancer Survival Rates by Stage
The stage at diagnosis is key in cancer survival rates. It helps patients and doctors make better choices. Looking at thyroid, prostate, and testicular cancers shows how important early detection is.
Early-Stage Survival Comparisons
Thyroid cancer diagnosed early has a five-year survival rate over 98%. Early prostate cancer has a nearly 100% five-year survival rate. Testicular cancer diagnosed early has a 95% five-year survival rate.
Early detection means more treatment options and better results. For example, thyroid cancer might just need surgery. Early prostate cancer could be watched closely or treated with radiation.
Advanced-Stage Survival Comparisons
But, advanced-stage cancer is tougher. Thyroid cancer at a distant stage has a five-year survival rate of about 55%. Advanced prostate cancer has a five-year survival rate of around 30%, thanks to new treatments. Testicular cancer at an advanced stage has a five-year survival rate of about 73%.
Knowing these survival rates helps manage patient hopes and treatment plans. Advanced cancers need stronger treatments like chemotherapy and targeted therapy.
By looking at these cancers at different stages, we see the importance of early detection. This info helps improve public health and patient education.
The Role of Early Detection in the Top 3 Cancers
Early detection is key to beating the top 3 cancers. It boosts survival chances and makes treatments work better. We’ll look at why early detection matters, screening tips, and signs to watch for.
Screening Guidelines and Recommendations
Screening rules help find cancers early. For thyroid, prostate, and testicular cancers, specific tests are suggested. For example, the Prostate-Specific Antigen (PSA) test is used for prostate cancer. Ultrasound and physical checks help spot testicular cancer. Following these guidelines can greatly help outcomes.
The American Cancer Society says men over 50 should talk to their doctor about PSA tests. For thyroid cancer, knowing your family history and radiation exposure can help spot risks.
“Early detection is key to surviving cancer. When we detect cancer early, we have a much better chance of treating it effectively.”
Warning Signs That Shouldn’t Be Ignored
Knowing cancer signs can lead to early detection. For thyroid cancer, a neck lump is a common sign. Prostate cancer might not show symptoms early, but later signs include trouble urinating or pain during ejaculation. Testicular cancer often shows as a painless lump or swelling.
It’s vital to watch for these signs and see a doctor if you notice anything unusual. Early detection can be lifesaving.
Understanding early detection and following screening guidelines can save lives. Being informed and proactive about health can make a big difference.
Treatment Approaches for Cancers with Highest Survival Rates
Effective treatments are key to high survival rates in some cancers. Medical advances have greatly improved patient outcomes.
Surgery and Radiation Therapy
Surgery and radiation therapy are main treatments for high survival cancers. Surgery removes tumors and affected tissues to get rid of cancer cells. New surgical methods, like minimally invasive surgery, help patients recover faster and have fewer complications.
Radiation therapy uses high-energy particles or waves to kill or damage cancer cells. It can be used alone or with surgery or other treatments. Modern radiation therapy is more precise, reducing harm to healthy tissues and making it more effective.
Hormone Therapy and Targeted Treatments
Hormone therapy and targeted treatments are also vital for managing high survival cancers. Hormone therapy is for cancers that grow in response to hormones, like some breast and prostate cancers. It blocks the body’s natural hormones, stopping cancer cells from growing.
Targeted treatments, including drugs, aim at specific cancer cell traits, sparing normal cells. This precision lowers the side effects of traditional chemotherapy.
These treatments, often used together, have greatly helped in achieving high survival rates in cancers like thyroid, prostate, and testicular cancer. Knowing how each treatment works is essential for creating effective cancer treatment plans.
Other Cancers with Promising Survival Statistics
Other cancers like melanoma, breast cancer, and childhood leukemia are showing better survival rates. This is thanks to early detection and new treatments. We’ll look at what’s behind these positive trends and the latest survival stats for these cancers.
Melanoma in Early Stages
Melanoma, a skin cancer, has seen big improvements in survival rates, mainly when caught early. New diagnostic tools and treatments have helped a lot.
Early-stage melanoma has a high survival rate, with five-year survival rates over 90% in many cases. Early detection and quick treatment are key to this success.
Breast Cancer with Early Detection
Breast cancer survival rates have gone up a lot, thanks to better screening and treatments. Finding breast cancer early is very important for managing it well.
When caught early, breast cancer has a much better survival rate. We’ve seen a big drop in deaths thanks to better screening and treatments.
Childhood Leukemia Success Stories
Childhood leukemia, like acute lymphoblastic leukemia (ALL), is now much more treatable. Survival rates have jumped a lot in the last few decades. Better chemotherapy and care have been key to this success.
The survival rate for childhood leukemia is now over 90% in many countries. This is thanks to clinical trials and new targeted therapies.
| Cancer Type | Early-Stage Survival Rate | Factors Contributing to Success |
| Melanoma | Over 90% | Early detection, advances in diagnostic techniques |
| Breast Cancer | Over 99% (localized) | Screening guidelines, effective treatments |
| Childhood Leukemia | Over 90% | Advances in chemotherapy, targeted therapies |
Lifestyle Factors That May Improve Cancer Outcomes
Research shows that lifestyle choices can boost cancer survival rates. As we learn more about cancer treatment, it’s clear that how we live affects our outcomes.
Nutrition and Physical Activity
Eating well and staying active are key for health, even more so for cancer patients. Good nutrition helps the body heal from treatment.
Eating fruits, veggies, whole grains, and lean proteins can help manage side effects. Some foods might even fight cancer, but we need more studies to know for sure.
| Food Group | Examples | Potential Benefits |
| Fruits | Berries, Citrus Fruits | Rich in antioxidants, vitamins |
| Vegetables | Leafy Greens, Cruciferous Vegetables | High in fiber, vitamins, and minerals |
| Whole Grains | Brown Rice, Quinoa | Rich in fiber, vitamins, and minerals |
| Lean Proteins | Chicken, Fish, Legumes | Supports muscle health, rich in essential nutrients |
Being active is also vital for cancer recovery. Exercise can lessen side effects, boost mood, and improve life quality. Aim for 150 minutes of moderate exercise like walking, cycling, or swimming each week.
Smoking Cessation and Alcohol Moderation
Quitting smoking is a big step for cancer patients. Smoking can make treatment less effective and raise the risk of cancer coming back. There are many resources to help quit, like counseling and medication.
Drinking in moderation is also key for cancer patients. Too much alcohol can increase cancer risk and hinder treatment. Stick to one drink a day for women and two for men.
By choosing healthy lifestyles, cancer patients can aid in their recovery and better outcomes. It’s important to talk to your healthcare team about your lifestyle choices to make the best decisions for your health.
Psychological Aspects of Surviving High-Survival Cancers
Cancer survival rates are getting better, and it’s clear we need to focus on the mind as much as the body. Surviving cancer means beating the physical battle and dealing with the emotional and mental side too.
Coping with Diagnosis and Treatment
Getting a cancer diagnosis can change your life, causing shock, denial, anxiety, and fear. Coping with the diagnosis is a big mental challenge for the patient and their family. It helps to have support, do things that reduce stress, and talk openly with doctors.
Treatment brings its own mental hurdles, like dealing with side effects, body image changes, and keeping up with daily life. Psychological support is key during treatment. This might include counseling, therapy, or other mental health help.
Long-term Survivorship Challenges
Surviving cancer isn’t just about finishing treatment. It’s about facing long-term challenges too. Survivors might worry about cancer coming back, feel anxious about their health, and struggle to get back to their old life. Long-term support is vital to help them cope and live better.
| Psychological Challenge | Coping Strategies |
| Fear of Recurrence | Mindfulness, Support Groups, Regular Follow-ups |
| Anxiety and Depression | Cognitive-Behavioral Therapy, Medication, Lifestyle Changes |
| Reintegration Challenges | Social Support, Counseling, Gradual Return to Activities |
By tackling the mental side of cancer survivorship, we can offer better care. This care supports the whole person, not just the disease. It’s key to improving life for cancer survivors and helping them through their journey.
Future Directions in Improving the Highest Cancer Survival Rates
New research and clinical trials are key to better cancer survival rates. They help us understand cancer better and find new treatments. This brings hope for better care and outcomes.
Emerging Research and Clinical Trials
Oncology is making big strides thanks to ongoing research and trials. Immunotherapy is a big hope, using the body’s immune system to fight cancer. Trials are important for checking if new treatments work and are safe.
Precision medicine is also growing, tailoring treatments to each patient’s cancer. This approach could lead to better survival rates and fewer side effects.
| Research Area | Description | Potential Impact |
| Immunotherapy | Harnessing the immune system to fight cancer | Improved survival rates |
| Precision Medicine | Tailoring treatments to individual cancer characteristics | Enhanced treatment efficacy |
| Targeted Therapies | Drugs designed to target specific cancer cells | Reduced side effects |
Potential Breakthroughs on the Horizon
Several breakthroughs could soon improve cancer survival rates. Gene editing technologies, like CRISPR, might fix cancer-causing genetic mutations. Also, liquid biopsies could help detect and track cancer earlier.
As research keeps advancing, we’ll see treatments that are more effective and less invasive. The use of artificial intelligence in cancer research could also lead to new treatments and better patient care.
What We Can Learn from Cancers with High Survival Rates
Learning from cancers with high survival rates can help us improve treatment for all cancers. By studying cancers like thyroid, prostate, and testicular, we find common success factors. These can be applied to other types of cancer.
Applying Success Factors to Other Cancer Types
High survival rates in some cancers come from early detection, advanced treatments, and good management. For example, prostate cancer screening has greatly improved outcomes. Targeted therapies have also made treatments more effective.
By using these strategies for other cancers, we can boost survival rates. More screening for lung and pancreatic cancer could lead to better treatment. Also, using new treatments like immunotherapy could help more people.
Key strategies for applying success factors include:
- Enhancing early detection through improved screening programs
- Developing and adopting more effective treatment protocols
- Improving patient access to advanced therapeutic options
Public Health Implications
Understanding and applying lessons from high-survival cancers is very important for public health. By sharing best practices in cancer care, we can reduce the global cancer burden. This means better treatment and fair access to care for everyone.
Studying high-survival cancers also helps us develop better cancer control strategies. By working together on prevention, detection, and treatment, we can improve outcomes for all cancer patients.
The chance to improve cancer survival rates is huge. As we learn more and apply these lessons, we can see big improvements in cancer care worldwide.
Conclusion
Looking at cancers with the highest survival rates, we see big improvements. This is thanks to new medical tech and better treatments. Thyroid, prostate, and testicular cancers have the best survival rates because of early detection and effective treatments.
Our key points show why knowing cancer survival rates is so important. We talked about how early detection and treatment options like surgery and radiation therapy play a big role. This helps patients live longer and better lives.
In the end, we see a bright future for cancer survival rates. This future is built on the success of these cancers. We can apply what we’ve learned to help more people fight cancer. Our final thoughts stress the need for more research and support for those battling cancer.
FAQ
What are the top 3 cancers with the highest survival rates?
The top 3 cancers with the highest survival rates are thyroid, prostate, and testicular cancer. These cancers have seen big improvements in survival rates. This is thanks to better treatments and catching them early.
How are cancer survival rates measured?
Cancer survival rates are measured by the five-year survival rate. This rate shows the percentage of patients alive five years after being diagnosed. There are also relative and absolute survival rates, which give a more detailed look at cancer outcomes.
What factors influence cancer survival outcomes?
Several factors affect cancer survival outcomes. These include the cancer’s stage, the patient’s demographics, and access to advanced treatments. Catching cancer early and treating it quickly greatly improves survival chances.
Why is thyroid cancer considered highly treatable?
Thyroid cancer is highly treatable because it grows slowly. Treatments like surgery and radioactive iodine work well. Early detection is key to treating thyroid cancer successfully.
What are the treatment options for prostate cancer?
Prostate cancer can be treated with surgery, radiation, hormone therapy, or active surveillance. The best treatment depends on the cancer’s stage and the patient’s health.
How has early detection impacted testicular cancer survival rates?
Early detection has greatly improved testicular cancer survival rates. Most testicular cancers are caught early. Quick treatment leads to high cure rates, even in advanced cases.
What lifestyle factors can improve cancer outcomes?
Eating well, staying active, quitting smoking, and drinking less alcohol can help cancer outcomes. These habits support health and make treatments more effective.
What are the psychological challenges faced by cancer survivors?
Cancer survivors often deal with anxiety, depression, and fear of cancer coming back. It’s important to have emotional and psychological support for long-term well-being.
What future directions are being explored to improve cancer survival rates?
New research, clinical trials, and treatments are being looked into to boost cancer survival rates. Advances in targeted therapies, immunotherapies, and precision medicine are promising.
How can success factors from cancers with high survival rates be applied to other cancer types?
Learning from cancers with high survival rates can help improve outcomes in other cancers. This includes using early detection, new treatments, and supportive care for more cancers.
What is the significance of relative survival rates in cancer statistics?
Relative survival rates give a clearer picture of cancer survival by comparing cancer patients to the general population. This metric helps understand cancer-specific mortality better.
How do global cancer statistics compare to U.S. cancer outcomes?
U.S. cancer outcomes are often as good as or better than global statistics, for cancers with high survival rates. But, there are disparities in cancer care and access to treatment both in the U.S. and worldwide.
Reference
- Sakr, R. A. (2023). Long-term survival in patients with cancers: Insights into key cancer types with high survival rates. PMC, National Center for Biotechnology Information. Retrieved from https://pmc.ncbi.nlm.nih.gov/articles/PMC10467541/